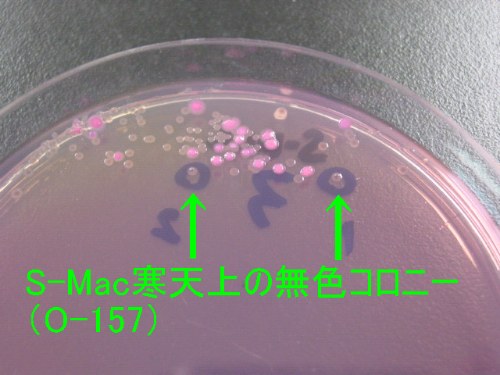

京都 花楽 食中毒

施設内研修会 夏場の食中毒予防について

新着情報 京都祇園の料理旅館 花楽公式サイト 京都市東山区の旅館

社会福祉法人京都社会事業財団京都桂病院 桂 栄養最前線 旬彩だより5月号
京都 花楽 食中毒 のギャラリー
料理旅館 花楽 の宿泊プラン 宿泊予約は 一休 Com キラリト

食中毒の発生について 乙訓食品衛生協会

花楽
感染症 食中毒の検査について 京都府ホームページ

京都市南区役所 食中毒を予防しましょう 市民しんぶん南区版 平成年9月15日号

料理旅館 花楽 宿泊予約 楽天トラベル

京都の京町家旅館 楽 遊 がクラウドファンディングcampfireにおいて支援プロジェクトをスタート アジア インタラクション サポート 外食業界の新店舗 新業態など 最新情報 ニュース フーズチャネル

昭和町の飲食店でアニサキスによる食中毒 2日間の営業停止 Utyニュース 山梨県昭和町の飲食店で寄生虫のアニサキス dメニューニュース Nttドコモ

草喰なかひがし 京都市左京区の完全予約制日本料理店

花楽

ノロウイルスによる食中毒に注意 精華町

刑務所で120人が食中毒で業務停止 受刑者が自ら調理
料理旅館 花楽 の宿泊プラン 宿泊予約は 一休 Com キラリト

診療案内 京都市伏見区の外科 内科 肛門科 皮膚科 岩田クリニック

社会福祉法人京都社会事業財団京都桂病院 桂 栄養最前線 旬彩だより5月号
唐揚げや鳥たたきで腹痛 4人グループ食中毒 焼き鳥店を営業停止に 社会 地域のニュース 京都新聞 ニュートピ Twitterで話題のニュースをお届け

舞鶴公衆衛生協会 食中毒発生状況

テイクアウト営業に関する注意点 ワイングロッサリーについて

舞鶴公衆衛生協会 食中毒発生状況

一度は訪れたい特別なカフェ 京都 岡崎 好日居 料理王国

株式会社 バイオ シータ 食品細菌迅速自動検査システム Dox Dox 60f Dox 30f 一般生菌 大腸菌 群 を迅速に測定 第61話 平成30年の食中毒の発生状況
ホテルルビノ京都堀川 宿泊予約は Yahoo トラベル

本当にハイクラス 松園荘 保津川亭の口コミ トリップアドバイザー
Www Fmfsm Com App Download 3 E7 Ab A0 E9 A3 9f E4 B8 Ad E6 Af 92 80 803 1 E5 Ae 9a E7 Be 80 803 2 E7 A8 Ae E9 A1 9e 80 803 3 E7 99 Ba E7 94 9f E7 8a B6 E6 8117b Pdf T Mobile 1

公益社団法人京都府食品衛生協会 お店に安全を お客様に安心を 京都府食品衛生協会

夏の食中毒にご用心 京都コムファ

料理旅館 花楽 の宿泊プラン 宿泊予約は 一休 Com キラリト

新型コロナウイルス除菌 殺菌 消毒のプロ業者 オーシーエルサービス 大阪 京都 滋賀 奈良 岐阜 愛知 三重 福井

京都の京町家旅館 楽 遊 がクラウドファンディングcampfireにおいて支援プロジェクトをスタート アジア インタラクション サポート 外食業界の新店舗 新業態など 最新情報 ニュース フーズチャネル

入会について 一般社団法人京都市食品衛生協会ホームページ

食事代行保証サービス 京都ケータリング株式会社

株式会社 バイオ シータ 食品細菌迅速自動検査システム Dox Dox 60f Dox 30f 一般生菌 大腸菌 群 を迅速に測定 第41話 少量感染による食中毒に厳重注意
2

大阪のラーメン店 歴史を刻め で食中毒 男女39人が腹痛や発熱 毎日新聞

料理旅館 花楽 宿泊予約 楽天トラベル

Ndxykoajouk0xm
新着情報 京都祇園の料理旅館 花楽公式サイト 京都市東山区の旅館

焼肉 弘 木屋町店 で食中毒 T T 京都てっぱん日記

舞鶴公衆衛生協会 食中毒発生状況

夏の食中毒にご用心 京都コムファ

刑務官の顔殴った疑い 受刑者を書類送検 社会 地域のニュース 京都新聞

食中毒の原因1位は 変なニオイや味がしなかったのに 刺身 白米に注意 菌の増殖対策とは 健康カプセル ゲンキの時間 インディー

京都刑務所で621人が食中毒 原因とみられるのは ハフポスト
新着情報 京都祇園の料理旅館 花楽公式サイト 京都市東山区の旅館

京都で修学旅行の31人に食中毒 一寸先は闇

京都で修学旅行の31人に食中毒 一寸先は闇

新着情報 京都祇園の料理旅館 花楽公式サイト 京都市東山区の旅館

切れ切れ爺さん 食中毒で大ダメージ その3 切れ切れ爺さんの徒然撮影 日記

ノロウイルス ミシュラン2つ星 草喰なかひがし で食中毒 京都てっぱん日記

花楽

ホテルと食中毒 橋本あれふ法律事務所

よくあるご質問 京都祇園の料理旅館 花楽公式サイト 京都市東山区の旅館

食中毒に注意しましょう 夏場は特に 健康 介護のまめ知識 医療法人高生会

滋賀県大津市 殺菌処理作業 食中毒予防で飲食店厨房内の消毒 京都のエアコンクリーニング 掃除 洗浄 京滋の清掃会社 Jp

京都で修学旅行の31人に食中毒 一寸先は闇
料理旅館 花楽 の宿泊プラン 宿泊予約は 一休 Com キラリト

花楽
食中毒対策に まな板に汚れがつかないシート まな板シート 使い捨て まな板汚れ防止 汚れ 色移り ニオイ移り 雑菌対策 食中毒対策 配送 ゆうパケット1 Ls1532 50 0c 9581 r Style 通販 Yahoo ショッピング

食中毒 京都のホテルルビノ京都堀川で茨城県日立市立泉丘中学の修学旅行生男女68人 まとめダネ
料理旅館 花楽 の宿泊プラン 宿泊予約は 一休 Com キラリト

料理旅館 花楽の口コミ 評判 宿泊予約は じゃらん
料理旅館 花楽 の宿泊プラン 宿泊予約は 一休 Com キラリト

京都市宇多野ユースホステル 日本ユースホステル協会公式

唯一無二の京和食 草喰 なかひがし のお昼のコースは懐かしさと感動を味わえる 京都ストーリー

長岡京市内の医療現場にunirウニールの人気ランチセットをお弁当にした ピヨ弁セット を無償提供 クラウドファンディングで500食の提供を目指す 株式会社ヒサシヤマモトコーヒーのプレスリリース

あんしんフード君 でよりトータルな対策を 公益社団法人京都府食品衛生協会

トピックス 京都府生活衛生営業指導センター Kyoto Seel

とろさば料理専門店 Sabar 京都烏丸店 四条烏丸 烏丸御池 魚料理 ぐるなび

料理旅館 花楽 宿泊予約 楽天トラベル

感染症 食中毒の検査について 京都府ホームページ

都道府県市食品衛生協会 講習会開催内容 ノロウイルス食中毒予防強化期間

焼肉 弘 グループで また食中毒 こんどは祇園の高級店 弘 八坂邸 京都てっぱん日記

両丹日日新聞 コロナで増えたテイクアウト導入店 京都府が食中毒予防の重点に ニュース

大阪 京都 神戸のケータリング オードブルなら南海ケータリングサービス お弁当 の大量オーダーを頂きました 大阪 京都 神戸のケータリング オードブルなら南海ケータリングサービス

料理旅館 花楽 宿泊予約 楽天トラベル

ミシュラン二つ星の 草喰なかひがし で食中毒が発生 19年12月27日発表 Naver まとめ

閉店 らーめん花楽 相模大野店 相模大野 ラーメンデータベース

これまでの 今年の漢字 を振り返る 写真特集23 24 毎日新聞

夏の食中毒にご用心 京都コムファ

Amazon 有機jas米から作られたぬか床 ぬかの花スタートセット 中 専用補充ぬか 3 4人用 京都 祇園料亭の味 超熟成 最高級贅沢素材 祇園ばんや 漬物の素 糠床 通販

老人ホームで57人食中毒 木更津 給食原因

食中毒の発生について 乙訓食品衛生協会

料理旅館 花楽 宿泊予約 楽天トラベル

運営情報 Next 洛楽 サービス付き高齢者向け住宅情報提供システム

普及啓発活動 一般社団法人京都市食品衛生協会ホームページ

新着情報 京都祇園の料理旅館 花楽公式サイト 京都市東山区の旅館
Www2 City Kyoto Lg Jp Rizai Chodo Info Pdf 30a 50 Pdf
2

切れ切れ爺さん 食中毒で大ダメージ その3 切れ切れ爺さんの徒然撮影 日記

京都で修学旅行の31人に食中毒 一寸先は闇
料理旅館 花楽 の宿泊プラン 宿泊予約は 一休 Com キラリト

滋賀刑務所で1人集団食中毒 受刑者が調理の給食原因 社会 地域のニュース 京都新聞

花楽

料理旅館 花楽 宿泊予約 楽天トラベル

京都市中京区で飲食店の店内清掃 厨房清掃ほか 京都のエアコンクリーニング 掃除 洗浄 京滋の清掃会社 Jp

花楽

新着情報 京都祇園の料理旅館 花楽公式サイト 京都市東山区の旅館